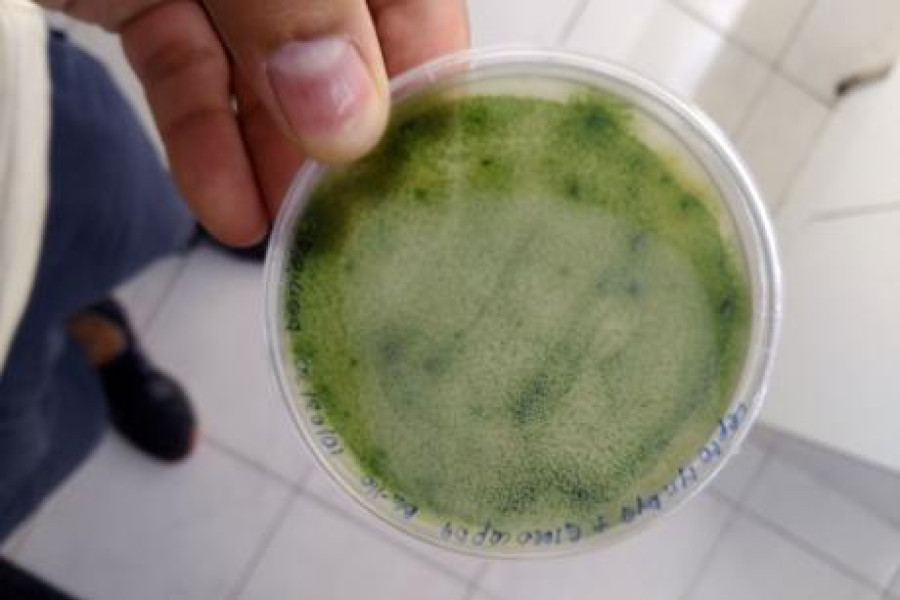

“Una tecnología lista para ser transferida” es la desarrollada en el laboratorio de bioquímica vegetal y fitorremediación producto de años de investigación y cuya primera etapa concluyó con el webinar que dio cierre al proyecto Fondef “Escalamiento y desarrollo de un bioestabilizador de material particulado para la operación sustentable de mina” dirigido por la investigadora de la Universidad de Santiago, Dra. Claudia Ortiz.
A diferencia de otros métodos que se aplican en la actualidad, el proyecto busca controlar la dispersión de contaminantes provenientes de depósitos de relaves mineros mediante la aplicación de un bioestabilizador consistente en cianobacterias, microorganismos capaces de formar costras biológicas de suelo y, por tanto, propiciar la germinación de plantas mediante la colonización de algas, hongos y bacterias propias de la zona.
“De esta forma su utilización implica una solución permanente, ambientalmente amigable y propone una mejora ambiental al contribuir fuertemente a mitigar los conflictos que rodean a la minería chilena a mediano plazo”, explicó la doctora Claudia Ortiz durante la presentación de cierre del proyecto.
Además de las ventajas que tiene su utilización, las características de las cianobacterias permiten, entre otras cosas, atrapar material particulado fino de manera más eficiente, además de evitar la contaminación de fuentes de agua generando impactos negativos en el medio ambiente y las personas.
Gracias al interés de compañías asociadas al proyecto como VialCorp S.A. - empresa que cuenta con más de diez años de experiencia en el tratamiento del control de polvo - y al apoyo de la Unidad de Dirección General de Transferencia Tecnológica dependiente de la Vicerrectoría de Investigación, Desarrollo e Innovación de la Universidad de Santiago, se espera proteger industrialmente la formulación a través de una solicitud de patente para, en una segunda etapa, ampliar su uso y probar su impacto durante su comercialización.
Más en Usach al Día
Una solución natural y sustentable para controlar la contaminación generada por la actividad minera fue presentada en el contexto del cierre del proyecto Fondef de la académica de la Facultad de Química y Biología, doctora en Ciencias Biológicas, Claudia Ortiz.
Redacción
Fotografía
Categoría